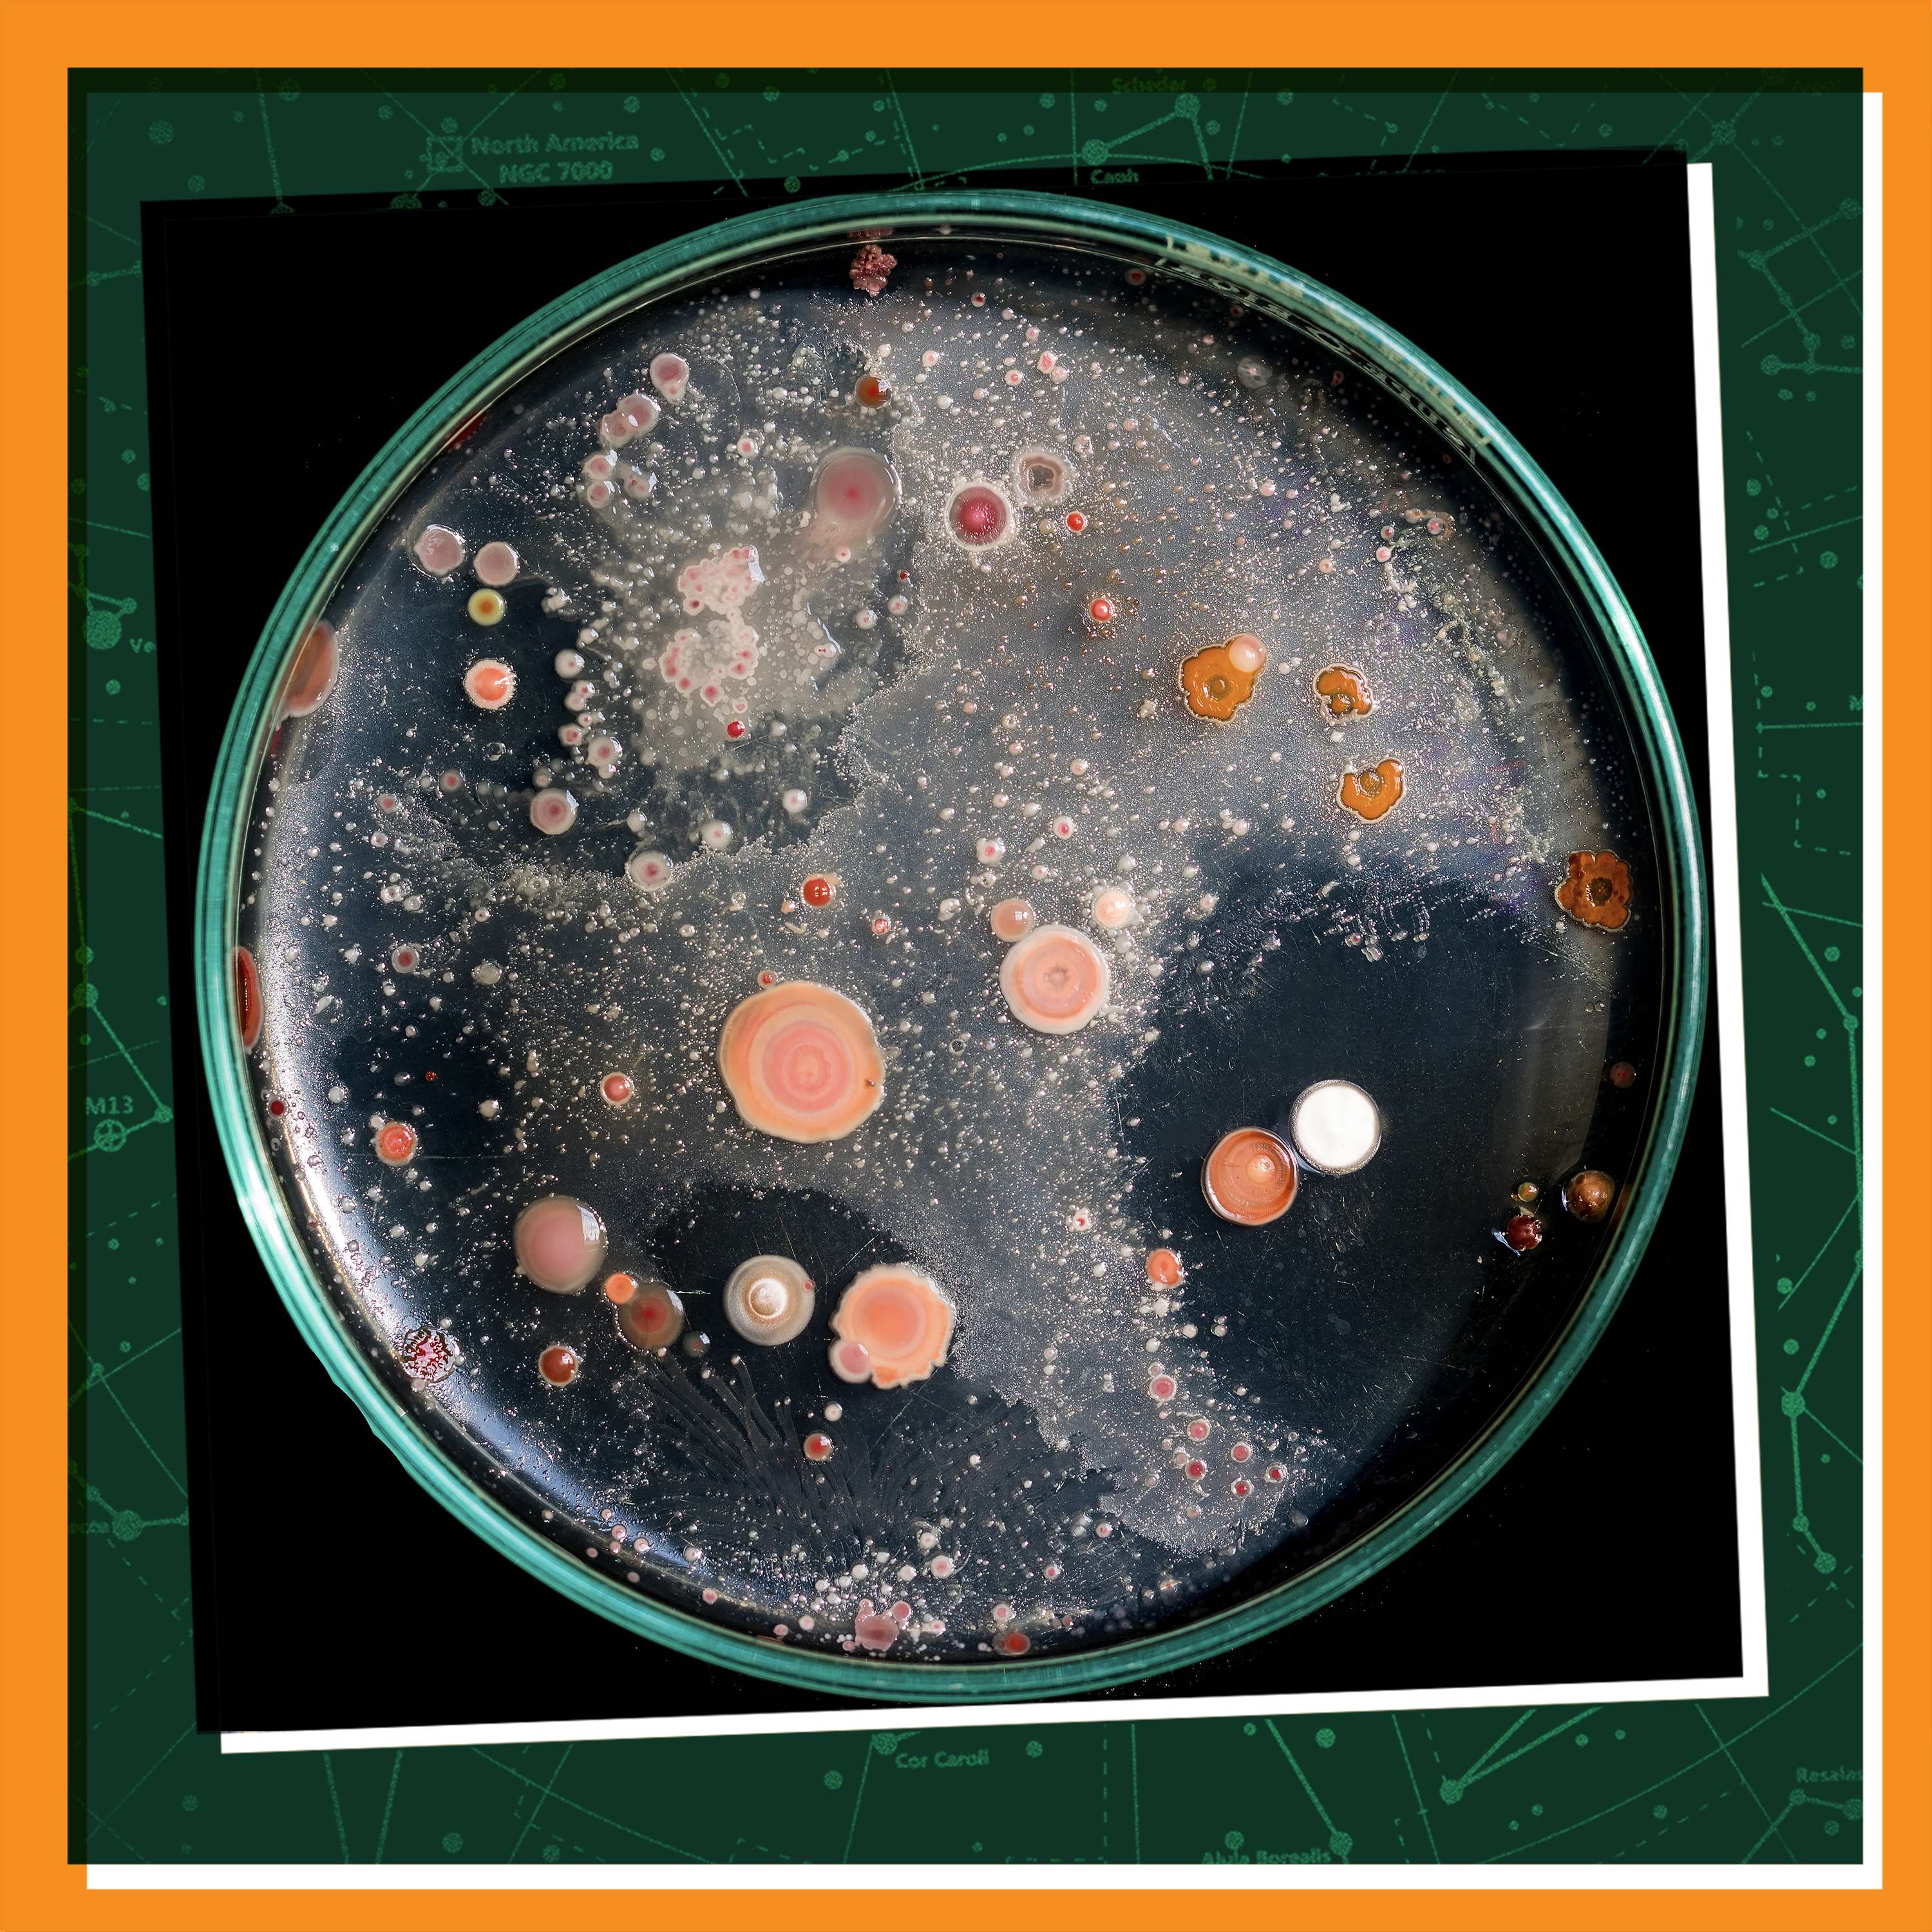

Aug 9, 2024
TRAILER: Constant Wonder KIDS — Nature Adventures for Young Explorers!
Welcome to Constant Wonder KIDS, the podcast that turns everyday moments into extraordinary adventures! Designed for curious kids (and the grown-ups who love them), our show takes you on thrilling journeys through the wonders of the natural world. Discover fascinating facts and true stories about amazing people doing incredible things in nature. Join us as we explore the playful side of octopuses who enjoy toys like Lego bricks. Dive into the ocean with whale sharks and meet one who has an unexpectedly friendly personality. Or cheer for tiny athletes at the International Hedgehog Olympic Games. Each episode of Constant Wonder KIDS is a bite-sized story taken from our parent podcast, Constant Wonder. Perfect for road trips, bedtime listening, or when your brain’s got an itch that needs to be scratched. Listen to Constant Wonder KIDS starting September 9, 2024. New episodes every Monday! Hosted by Paige Krumperman, Constant Wonder KIDS is a BYUradio podcast.
Dec 8
Winter Wonders: Meeting Wolves in the Far North
Arctic explorer Jon Waterman has spent years traveling through some of the coldest, wildest landscapes on Earth—places where wolves still roam free. In this Winter Wonders mini-episode, he shares his surprising encounters with these intelligent animals and their life in the true North. Guest: Jon Waterman, author of "Into the Thaw: Witnessing Wonder Amid the Arctic Climate Crisis"
Dec 15
Winter Wonders: Get Silly with Penguins
Field biologist Naira de Gracia has spent seasons working in Antarctica’s icy world, where penguins rule the shoreline. In this Winter Wonders mini-episode, she shares her close-up encounters with these hardy, hilarious birds and what she learned in the coldest place on Earth. Guest: Naira de Gracia, field biologist and Antarctic researcher
Dec 1
Winter Wonders: Life with Leopard Seals
While working as a field biologist in Antarctica, Naira de Gracia sometimes crossed paths with one of the continent’s most impressive animals—the leopard seal. In this Winter Wonders mini-episode, hear her stories of unexpected close encounters and life in the frozen south. Guest: Naira de Gracia, field biologist and author of "The Last Cold Place: a Field Season Studying Penguins in Antarctica"
1d ago
Winter Wonders: A Polar Bear Surprise on Arctic Waters
While kayaking through the remote Arctic, explorer and author Jon Waterman had an unforgettable—and unexpected—meeting with a wild polar bear. In this Winter Wonders mini-episode, Jon shares the heart-pounding moment, what he learned about these powerful predators, and how the experience shaped his understanding of the rapidly changing Arctic. Guest: Jon Waterman, author of Into the Thaw: Witnessing Wonder Amid the Arctic Climate Crisis
Nov 24
The Snowflake Man
Wilson Bentley loved snowflakes so much that he spent his life trying to understand them—catching them gently and photographing their beautiful, intricate shapes. Discover how his curiosity and patience helped the world see snowflakes in a whole new way. Guest: Wayne Howe, President of the Jericho, Vermont Historical Association
Nov 17
The Wild Sounds Around Us
Biologist and author David Haskell listens closely to the sounds of nature—from bugs chewing leaves to wind singing through trees. Discover how tuning in to nature’s music helps us understand and connect with the world around us. Guest: David Haskell, Biologist and Author of Sounds Wild and Broken Link to Season 4 Printable: https://www.byuradio.org/c8fae09b-f976-4649-b45f-418575c09804
Nov 10
A Baby Whale's Journey Home
When a young orca named Springer was found alone and far from her family, veterinarians, whale experts, and volunteers worked together to help her heal. With care, teamwork, and a little luck, Springer found her way back home to her ocean family! Guest: Donna Sandstrom, Founder and Executive Director of The Whale Trail Link to Season 4 Printable: https://www.byuradio.org/c8fae09b-f976-4649-b45f-418575c09804
Nov 3
Have You Ever Crawled Through Nature?
Biologist and author Thor Hanson loves to explore the outdoors—and he says the best discoveries happen when you slow down and really look. Learn how paying attention to the small wonders around you can make any walk an adventure! Guest: Thor Hanson, Biologist and Author Link to Season 4 Printable: https://www.byuradio.org/c8fae09b-f976-4649-b45f-418575c09804
Oct 27
A Panda and Her Friend
When giant panda Qian Qian needed help, conservation biologist Jake Owens was there—first as her teacher, then as her rescuer, and always as her friend. Discover how their special bond helped Qian Qian heal and thrive. Guest: Jake Owens, Conservation Biologist and Director of Conservation at the Los Angeles Zoo Link to Season 4 Printable: https://www.byuradio.org/c8fae09b-f976-4649-b45f-418575c09804
Oct 20
Using Our Senses Like Animals
We use our sense of sight, smell, sound, taste, and touch to understand the world and animals do, too! Jackie Higgins explains how even though our bodies are different, humans and animals have more in common than you might think. Guest: Jackie Higgins, author of "Sentient: How Animals Illuminate the Wonder of Our Human Senses" Link to Season 4 Printable: https://www.byuradio.org/c8fae09b-f976-4649-b45f-418575c09804
Oct 13
Getting to Know Intraterrestrial Microbes!
You might think you know about life on earth, but scientist Karen Lloyd knows where to find tiny microbes that are anything but ordinary. Meet the microbes who live in the extremes! Guest: Karen G. Lloyd, Wrigley Chair in Environmental Sciences, Professor of Marine and Environmental Sciences at the University of Southern California Link to Season 4 Printable: https://www.byuradio.org/c8fae09b-f976-4649-b45f-418575c09804
Oct 6
The Secret Sounds of Elephants and Volcanoes
Undetectable to human ears, infrasound can teach us more about how elephants communicate and when volcanoes erupt. Join scientists Jeffrey Johnson and Caitlin O’Connell-Rodwell to learn more about infrasound. Guests: Caitlin O’Connell-Rodwell, instructor at Harvard Medical School, elephant expert, and founder and CEO of Utopia Scientific Jeffrey Johnson, associate professor of Geoscience at Boise State University
Sep 29
Walking 500 Miles to Help a Bird in Trouble
Curlews used to be a beloved part of the English landscape, but in the past century, these fascinating birds have been disappearing. Conservationist Mary Colwell decided to walk 500 miles to raise awareness for the birds she loves. Guest: Mary Colwell, Director of Curlew Action, conservationist, author of “Curlew Moon”
Sep 22
The Search for a Sunken Ship
Over 100 years ago, explorer Ernest Shackleton’s ship The Endurance sank to the bottom of the sea. Join archaeologist Mensun Bound to hear about how he set sail to find the lost Endurance. Guest: Mensun Bound, archaeologist and Director of Exploration on the 2019 and 2022 expeditions to locate Shackleton’s Endurance
Sep 15
Super Plants in the Amazon
Can plants fight off infections? Ethnobotanist Cassandra quave takes us into the rainforest to discover amazing plants and how they can help take care of human bodies. Guest: Cassandra Quave, author of “The Plant Hunter: A Scientist’s Quest for Nature’s Next Medicines” and Associate Professor of Dermatology and Human Health at Emory School of Medicine
Sep 8
A Vet at the Edge of the Earth
As a vet on faraway islands, Joe Hollins is used to an element of adventure when caring for animals. Whether he’s helping a herd of skittish reindeer or caring for a tortoise born in the 1800s, Joe knows that humans can make a difference when helping animals. Guest: Jonathan Hollins, author of “Vet at the Edge of the Earth: Adventures with Animals in the South Atlantic”
Jul 7
Chicken Talk and Friendly Flocks
Sy Montgomery shares her most recent group of animal friends- a flock of chickens! Learn about how chickens think and behave and what we can do to experience wonder through our animal neighbors.
Jun 30
Inside the Mind of a Bee
A bee brain might be tiny, but Dr. Lars Chittka knows there’s a lot more to these buzzing pollinators than meets the eye. Learn how bees can solve problems, play with toys, and even feel emotions! Guest: Lars Chittka, professor of Sensory and Behavioral Ecology at Queen Mary University of London and author of “The Mind of a Bee”
Jun 23
How to Grow a Naturalist
When Paula Whyman first started working on the land in her backyard, she had no idea how to turn it into a healthy ecosystem! With lots of help and hard work, Paula is now growing into the title of "naturalist"- and you can, too! Guest: Paula Whyman, author of “Bad Naturalist: One Woman’s Ecological Education on a Wild Virginia Mountaintop"
Jun 16
Say Cheese, Hummingbird!
Eric Pittman loves taking pictures of the hummingbirds in his backyard. Over the years, he’s become a citizen scientist, documenting hummingbird societies up close and learning more about these amazing little birds. Guest: Eric Pittman, Hummingbirds Up Close Photo credit: Eric Pittman Hummingbird audio courtesy of Eric Pittman HUMMINGBIRD VIDEO HERE: https://www.instagram.com/reel/DJXdtoJzsjb/?igsh=NTcxY3FhZGVwdHlm
Jun 9
When Botanists Braved the Colorado
In 1938, the raging rapids of the Colorado River were untamed and the plants that grew there were unknown. Two botanists, Alzada Clover and Lois Jotter, set out to document the plants and in doing so became the first known women to raft the Colorado River. Guest: Melissa Sevigny, author of “Brave the Wild River: The Untold Story of Two Women Who Mapped the Botany of the Grand Canyon.” PRINT YOUR COLORING PAGE HERE: https://bit.ly/cwk_adventure You can send pictures of your art to constantwonder@byu.edu!
Jun 2
Wild Ways Animals Battle to Win
In the animal kingdom, creatures big and small fight to get what they need to survive. Join us as Lee Dugatkin, an expert on animal interactions, explains how different species battle it out in the wild. Guest: Lee Dugatkin, professor of biology at the University of Louisville and author of “Power in the Wild: The Subtle and Not-So-Subtle Ways Animals Strive for Control over Others” PRINT YOUR COLORING PAGE HERE: https://bit.ly/cwk_adventure You can send pictures of your art to constantwonder@byu.edu!
May 26
Become a Crewmate on Spaceship Earth
As a NASA astronaut, Nicole Stott has been a crewmate on two different missions to the International Space Station. It was in space that she realized that we are all crewmates- crewmates on Spaceship Earth! Guest: Nicole Stott, retired NASA astronaut; author of “Back to Earth: What Life in Space Taught Me About Our Home Planet- And Our Mission to Protect It”; Founding Director of the Space for Art Program PRINT YOUR COLORING PAGE HERE: https://bit.ly/cwk_adventure You can send pictures of your art to constantwonder@byu.edu!
May 19
Night Magic
Leigh Ann Henion knows that when the sun goes down, nocturnal creatures come out to enjoy the nighttime world. Salamanders, fireflies, moths, and moon gardens are all part of this night magic! PRINT YOUR COLORING PAGE HERE: https://bit.ly/cwk_adventure You can send pictures of your art to constantwonder@byu.edu!
May 12
Diving Deep
Zandile Ndhlovu didn’t grow up spending time in the ocean, but once she gave it a try, she never wanted to stop! Now she’s a free diving instructor, dedicated to helping her community become more comfortable in the underwater world. PRINT YOUR COLORING PAGE HERE: https://bit.ly/cwk_adventure You can send pictures of your art to constantwonder@byu.edu!
May 5
A Real-Life Treasure Hunt
As a National Geographic explorer, Alastair Humphreys has gone on adventures all over the world. For a year, he gave himself a new quest—experience adventure and wonder, without leaving his town’s map. Guest: Alastair Humphreys, National Geographic Explorer and author of "Local: A Search for Nearby Nature and Wildness" PRINT YOUR COLORING PAGE HERE: https://bit.ly/cwk_adventure You can send pictures of your art to constantwonder@byu.edu!
Apr 28
The Funky World Under Your Feet
Sasha Reed studies a community in that natural world that you’ve probably never heard of before- biocrust. Made up of lichen, algae, moss, and bacteria, this funky world beneath your feet is full of wonder! PRINT YOUR COLORING PAGE HERE: https://bit.ly/cwk_adventure You can send pictures of your art to constantwonder@byu.edu!
Apr 21
A Hare in the House
Chloe Dalton was used to living in the big, busy city, but when she relocated to a small town in Northern England, her new neighbors drew her attention to the outdoors. Discover the wonder of wild hares! Guest: Chloe Dalton, author of “Raising Hare: A Memoir” PRINT YOUR COLORING PAGE HERE: https://bit.ly/cwk_adventure You can send pictures of your art to constantwonder@byu.edu!
Apr 14
Getting to Know Penguins in Antarctica
In Antarctica, slap-happy penguins and adorable fur seals roam free. As part of a crew studying penguins, Naira de Gracia spends time up close and personal with these amazing creatures, getting to see the world through their eyes. Guest: Naira de Gracia, field biologist and author of “The Last Cold Place: A Field Season Studying Penguins in Antarctica" https://bit.ly/cw_ColoringPage You can send pictures of your art to constantwonder@byu.edu!
Apr 7
Get Curious About Seahorses
Since he was a teenager, Neil Garrick-Maidment has had a knack for finding and caring for seahorses. Scientists once thought seahorses couldn’t live in cold water, but Neil knew he just had to put on his scuba suit to prove them wrong. Guest: Neil Garrick Maidment, Found of the Seahorse Trust https://bit.ly/cw_ColoringPage You can send pictures of your art to constantwonder@byu.edu!
Mar 31
Guiding Migrating Birds Home
Northern bald ibises have been extinct in the wild for 400 years, until a group of Austrian scientists attempted to re-introduce the birds to the wild. When attempting to migrate, the bald ibises had no idea where to go… until conservationist Johannes Fritz hopped in a microlight airplane and showed them the way. Guest: Johannes Fritz, biologist, conservationist, and founder of the Waldrappteam Photo copyright of the Waldrappteam https://bit.ly/cw_ColoringPage You can send pictures of your art to constantwonder@byu.edu!
Mar 24
Being Brave in the Natural World
Lyanda Lynn Haupt’s mission is to help people connect with the natural world, but that doesn’t mean she’s always comfortable outdoors. Sometimes experiencing wonder means learning to be brave, like camping all on our own or meeting wild animals when we least expect it. Join us to talk about stepping out of our comfort zones to feel awe! Guest: Lyanda Lynn Haupt, naturalist and author of “Rooted: Life at the Crossroads of Science, Nature, and Spirit”
Mar 17
Discover the World of Nematodes
Nematodes are microscopic worms that can be found all over the planet. Though they may be tiny, their impact is anything but small. Join scientists Byron Adams and Adler Dillman as they introduce us to the wonder of nematodes! Guests: Byron Adams, biology professor at Brigham Young University Adler Dillman, nematology professor at UC Riverside Coloring Page: https://www.byuradio.org/blog-post/d49be753-7cda-45e8-8648-49fda27bfc10/its-a-brand-new-season-and-we-need-your-help-to-chart-it
Mar 10
Healing Turtles, Healing the World
Turtles face lots of obstacles in the wild world, so it’s a lucky thing they’re born tough! Turtle-lovers Matt Patterson and Sy Montgomery have witnessed turtles come back from extraordinary injuries as they’ve worked with the Turtle Rescue Center in Southbridge, Massachusetts. These turtles prove that even broken things can be made right again. Guests: Sy Montgomery, author, and Matt Patterson, illustrator, of “Of Time and Turtles: Mending the World, Shell by Shattered Shell” Coloring Page: https://www.byuradio.org/blog-post/d49be753-7cda-45e8-8648-49fda27bfc10/its-a-brand-new-season-and-we-need-your-help-to-chart-it
Mar 3
Do Plants Think?
We all know plants are living things just like us, but do we have even more in common? Join us as we talk with science-writer Zoë Schlanger about how plants seem to communicate, hear, see, and yes, even think! Guest: Zoë Schlanger, science writer for The Atlantic and author of The Light Eaters: How the Unseen World of Plant Intelligence Offers a New Understanding of Life on Earth
Feb 24
Going Undercover to Save Sloth Bears
Kartick Satyanarayan has always loved animals and worked hard to protect wildlife. When he learns about sloth bears who are forced to “dance” in dangerous conditions, he decides to go undercover to save sloth bears and help humans along the way. Guest: Kartick Satyanarayan, Co-Founder and CEO of Wildlife SOS
Feb 17
A Quest for 1000 Plants
When enthusiastic nature-lover Mike Dilger was stuck at home during Covid, he came up with his next big project: finding 1000 plants across Great Britain in one year. Listen in as Mike tells us about his adventures while accomplishing his goal, as well as his general love for the natural world. Guest: Mike Dilger, BBC Presenter and author of “One Thousand Shades of Green”
Feb 10
Discovering Fireflies
Lynn Faust has always loved to watch fireflies at her family cabin. When she discovers that these fireflies are unknown in the scientific community, she sets out to share her family lightning bugs with the world. Guest: Lynn Faust, author of “Fireflies, Glow-worms, and Lightning Bugs: Identification and Natural History of the Fireflies of the Eastern and Central United States and Canada"
Feb 3
Saving Baby Peregrine Falcons
Peregrine falcons are the fastest animals in the world, but when baby peregrines start going missing, George Smith has the data and expertise to track down the chick-nappers. Guest: George Smith, Peregrine Coordinator for the Scottish Raptor Group
Jan 27
Arctic Explorer
Though cold and remote, the Arctic is explorer Jonathan Waterman’s favorite place. His encounters with bears, caribou, and beautiful landscapes introduce you to the Arctic through an adventurer’s eyes. Guest: Jonathan Waterman, author of "Into the Thaw: Witnessing Wonder Amid the Arctic Climate Crisis."
Nov 11, 2024
Owl and Me
When Carl met Alfie the baby owl, she was sick and about to die. With his help, Alfie grew healthy and strong, proving that good comes when we help animals one by one. Guest: Carl Safina, author of “Alfie and Me: What Owls Know, What Humans Believe" and Professor for Nature and Humanity at Stony Brook University
Nov 4, 2024
River Snorkeling
You might think that snorkeling is just for coral reefs, but Keith Williams knows that we can see amazing wildlife when we snorkel in the rivers and streams near our homes! Get to know candy darters, salmon, and other interesting freshwater creatures. Guest: Keith Williams, author of "Snorkeling Rivers and Streams: An Aquatic Guide to Underwater Discovery and Adventure" and guide at Freshwater Journeys
Oct 28, 2024
The Batman of Mexico
Listen to bat-lover Rodrigo Medellin share his love for the flying mammals. Known as the Batman of Mexico, his enthusiasm and love for bats make him their greatest defender. Guest: Rodrigo Medellin, Professor of Ecology at the National Autonomous University of Mexico
Oct 21, 2024
The Wonder of Poop
Poop might seem gross or silly to you, but to Joe Roman, poop is an important part of our ecosystems and a reason to feel awe and wonder. Guest: Joe Roman, author of "Eat, Poop, Die: How Animals Make Our World"
Oct 14, 2024
Making Peace in the Wolf Wars
Wolves and ranchers are constantly in conflict, with wolves hunting cattle and ranchers hunting wolves. Despite their differences, Daniel Curry wants to help both sides and be a peacemaker in the Wolf Wars. Guest: Daniel Curry, range rider and wolf advocate in Eastern Washington
Oct 7, 2024
Animal Doctors Help Gorillas AND Humans!
Gorillas, elephants, and hippopotamuses need wildlife veterinarians to help them stay healthy. But wildlife vets help humans, too! Dr. Gladys helps gorilla and human communities in Uganda stay safe from diseases and build a brighter future. Guest: Dr. Gladys Kalema-Zikusoka, veterinarian and public health expert
Sep 30, 2024
Making Friends with Octopuses
Octopuses are unique, intelligent creatures with mind-boggling abilities like shape-shifting and camouflage. But for Sy Montgomery, the most interesting thing about octopuses are their fun personalities and the friendships she's developed with them. Guest: Sy Montgomery, naturalist and author
Sep 23, 2024
Learning from Baby Elephants
When a baby elephant's mother is killed by poachers, she is brought to the Reteti Elephant Sanctuary. Listen to stories from this amazing place where humans save animals and sometimes, animals save humans, too. Guest: Ami Vitale, National Geographic photographer and filmmaker
Sep 16, 2024
Hedgehog Love
Meet Hedgehog Hugh—he's a conservationist who loves and studies... hedgehogs! Listen to how he discovered his favorite animal and how his love of hedgehogs helps to make the world a better place. Guest: Hugh Warwick, spokesperson for the British Hedgehog Preservation Society
Sep 9, 2024
A Daring Gi-Raft Rescue
When endangered giraffes are trapped on an island, conservationist David O’Connor needs to find a way to help them. Working as a team, David and local wildlife support build the first-ever raft for giraffes: the Gi-Raft! Guest: David O’Connor, President of Save Giraffes Now Photo credit: Ami Vitale
Sep 9, 2024
Make Some Animal Music
Can animals play duets with humans? Listen as David Rothenberg makes beautiful music with birds and whales. You won't believe your ears! Guest: David Rothenberg, composer, author, and professor of music and philosophy at the New Jersey Institute of Technology
Sep 9, 2024
Sharks Need Our Help!
Sharks are known as scary creatures, but to Rachel Graham, they’re charming friends who need our help. Get to know some of Rachel’s shark friends and hear how she helped inspire her human friends to help endangered sharks. Guest: Rachel Graham, Founder and Executive Director of MarAlliance